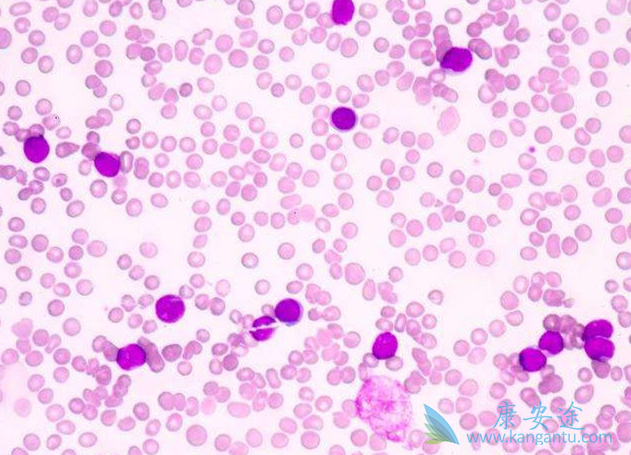
�ܰͰ�֢״

淋巴癌也叫“淋巴瘤”,是原发于淋巴结或淋巴组织的恶性肿瘤,是我国常见的十大恶性肿瘤之一,因为淋巴遍布全身,所以在很大程度上也增加了治疗的难度,所以大家一定要提前了解一下淋巴癌症状,如果在自己身上发现对应症状,一定要及时到医院进行检查。
1、全身淋巴结肿大:以颈部为主,其次为腋窝、腹股沟淋巴结,晚期可累及纵膈淋巴结。2、脾肿大:约30%累及于脾,多出现于后期,一般为反应性增生,或肉芽肿形成。3、造血系统:呈贫血象,与骨髓受累有关,晚期可出现溶血性贫血。4、消化系统:约30%有胃、胰、肠受累,可有吸收不良,甚至腹水症状。5、心血管系统:偶有渗出性心包炎。6、肝损坏:可由于肝损坏而导致黄疸。7、骨转移:约5~15%,出现骨痛。8、肾受累:约13有肾浸润,严重出现肾衰。9、肺浸润:胸腔积液为多,可占13~23%。10、全身症状:发热(呈不规则型),盗汗,瘙痒,尤其瘙痒为何杰金氏病的特异症状。
除了了解淋巴癌症状,了解淋巴癌的起因也很重要,这样才能有效规避风险。1、化学物质。化学物质很多人却经常接触,包括多环芳烃类化合物、烷化剂、芳香胺类都会导致淋巴癌的发生,一般新装修的家都会有很多此类此类致癌物质。2、免疫缺陷。免疫力低下可导致淋巴癌,,特别是病毒感染,导致淋巴癌侵袭,所以提升免疫力很重要。3、辐射。有些因为工作所以要长期接受辐射的人群要注意,应及时做好防癌措施,辐射容易导致淋巴癌的发生。4、感染。免疫力低下的人容易受到病毒感染,淋巴癌患者常常受感染的病毒有很多。
详情请访问 肿瘤 https://www.kangantu.com/














请简单描述您的疾病情况,我们会有专业的医学博士免费为您解答问题(24小时内进行电话回访)